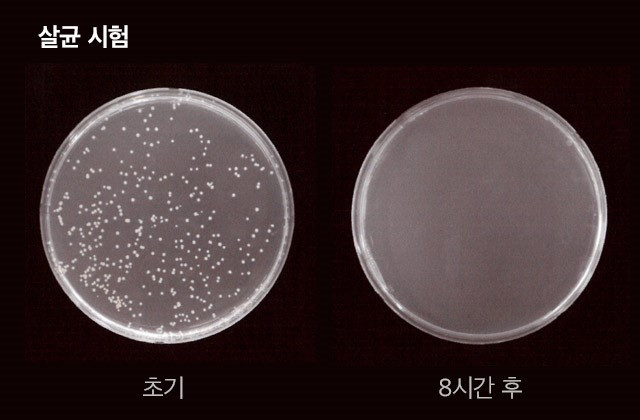
img_20180719174138_60b77626.jpg

뽐뿌오게 만드는 여름철 필수템 Best 5!
꿉꿉하고 덥고, 지치는 여름철, 여름을 극복하기 위한 팁을 가져왔다.
바캉스 갈 때 혹은 꿉꿉한 여름 집에서 홈캉스를 즐길 때 이런 제품들과 함께라면 여름도 즐거워질 듯 하다. 여름철 밖에서도 집안에서도 삶을 행복하게 해줄 ‘행복필수품’ 모아봤다.
1. 물놀이가 즐거워지는 카카오프렌즈 썸머 아이템!
#대형 라이언 페이스 매트튜브
귀여운 라이언 얼굴의 매트튜브 하나면 어디를 가든 시선 집중이다.
크키가 무려 180cm*150cm 라니, 왠만한 성인들도 누울 수 있는 크기다.

서핑보드 형태의 매트튜브도 인기다. 라이언과 어피치로 구성돼 원하는 캐릭터로 선택할 수 있다. (지금보러가기)
#대형 프루티프렌즈 비치타올
물 밖에서 잠시 쉴 때 두르거나, 모래사장 위에서 깔고 앉기도 하는 실용만점의 카카오프렌즈 원형 비치타올도 있다. 해변, 수영장, 계곡에서 깔개로도 젖은 몸을 닦을 비치 타올로도 사용이 가능하다.

원형 디자인으로 사랑스러운 분위기를 연출할 수 있다. 라이언 페이스 매트튜브와 함께 준비한다면 더욱 찰떡궁합이다. 카카오프렌즈 덕후라면 반드시 눈여겨봐야 할 아이템이다. (지금보러가기)
2. 다이어트 중이라면 딱! 칼로리 낮은 아이스크림 '스키니피그'
칼로리가 낮으면 맛이 없다는 편견을 깬 아이스크림이 화제다. 카카오메이커스에서 판매중인 '스키니피그(Skynny Pig)'다.

아이스크림의 파인트 사이즈 한 통의 칼로리는 기존 아이스크림의 20~25% 수준인 210~310kcal에 불과하다. 혈당치에 영향을 주지 않는 스테비아, 알룰로스 등 천연 감미료를 사용해 칼로리를 낮췄다.

캐릭터와 패키지는 국내 디자인 스튜디오 ‘코우너스’와 독일의 일러스트 작가 ‘Jochen Schievink’와의 협업으로 만들어 특별함을 더해준다.
스키니피그는 카카오메이커스에서 91%의 구매자가 만족 할 만큼 인기를 얻고 있다. (지금 보러가기)
3. “신발 냄새도 싹~” 여름철 꿉꿉한 냄새 잡는 ‘깨비스틱’

카카오메이커스의 인기템 ‘깨비스틱’은 집안의 신발 속, 화장실, 거실, 부엌 등에서 자주 발생하는 악취를 제거하고 살균 효과를 주는 제품이다. 이산화염소를 발생시켜 유해세균의 증식을 막고, 부패균에 의해 발생되는 악취를 제거해준다. (바로가기)
‘깨비스틱’은 작고 슬림한 스틱 형태다. 신발 속에 쏙 넣기 적당한 크기다. 화장실에도, 거실에도, 부엌에도 비치해 냄새도 잡고 세균도 잡아 보자.

스틱을 ‘딱’ 소리가 날 때까지 구부리면 화학 반응을 통해 제 성능을 발휘한다. 투명한 액체가 노란색으로 변하는 것을 눈으로 확인할 수 있다. 스틱의 액체가 노란색으로 변하기 시작하면 가볍게 흔든 뒤, 원하는 곳에 세워두기만 하면 된다.
4. “여름철 김치 냄새 우엑ㅠㅠ" 클레어V 냉장고 탈취기

김치냉장고에 김치 외에 다른 것을 넣었다가 낭패를 본 경험이 있는가?
클레어V 냉장고 탈취기만 있으면 김치냉장고의 김치 냄새를 줄일 수 있다. 클레어V는 단순히 탈취만 해주는 것이 아니라 세균을 제거하는 제품으로 냉장고 속 위생을 개선할 수 있어 인기가 높다.

카카오메이커스에서 26회째 재주문을 받고 있으며 무려 2217개의 후기를 자랑하는 클레어V! 구매자의 90%가 만족한 제품이기도 하다. (지금보러가기)
5. 칫솔 헤드만 넣으면 끝! USB 충전식 ‘휴대용 칫솔 살균기’

세균 번식이 더 활발해지는 여름철에 휴대가 편리한 칫솔 살균기를 써보는 건 어떨까. 칫솔 헤드만 넣어도 되는 작은 크기에 USB 충전방식을 적용해 한번 충전으로 20회까지 지속 사용이 가능하다. 치아와 잇몸 건강을 지키기 위해 사용해 보는 것도 좋다.
현재 메이커스에서 5000명이 주문해 주문은 종료된 상태다. 재주문 알림 받기를 신청해두면 다음 주문이 시작될 때 알림을 받을 수 있다. (지금보러가기)